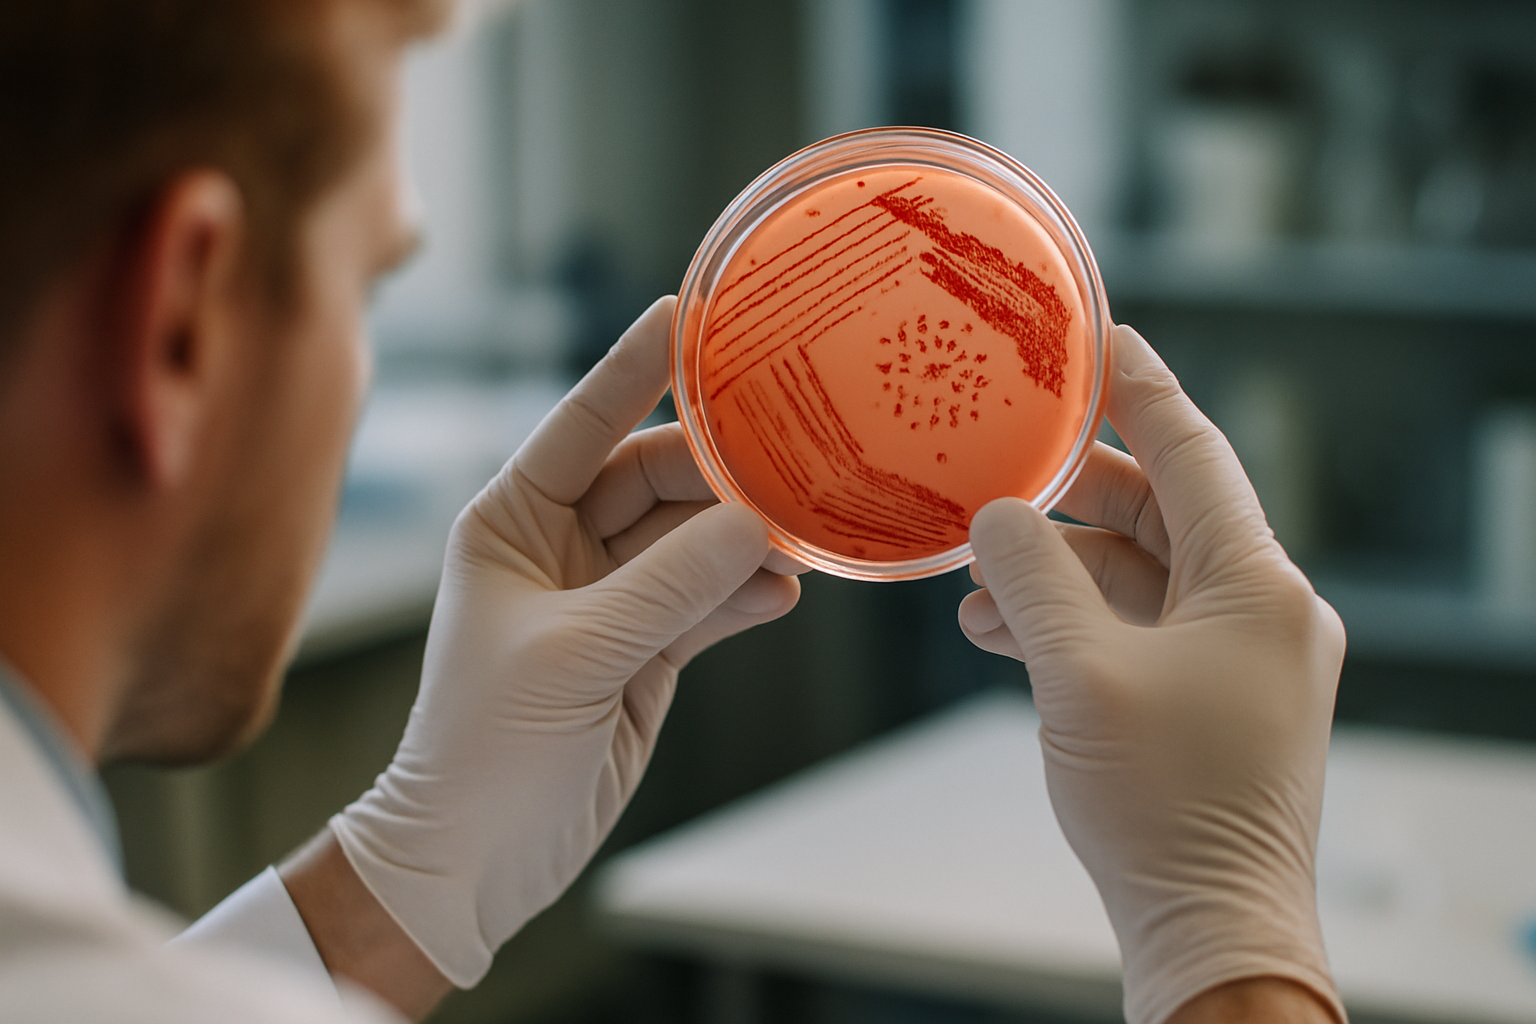
Yara Expande Centro de Pesquisa na Alemanha para Inovações em Agricultura Biológica

Polícia Federal Rastreia Esquema de Lavagem de Dinheiro com R$ 500 Milhões em Fraudes
Grupo criminoso, incluindo organizações como Fictor e Comando Vermelho, montou uma estrutura ampla para ocultar recursos ilícitos.
Ler Mais
Agropecuária Brasileira: O Protetor da Inflação em Risco com Conflito no Oriente Médio
Polo Capital indica que o cenário favorável pode ser alterado com a escalada da guerra.
Ler Mais
Alternativa de Escoamento: Ministério da Agricultura Se destaca com Rota Via Turquia
Novo certificado garante a continuidade das exportações brasileiras rumo ao Oriente Médio e Ásia Central.
Ler Mais
Yara Expande Centro de Pesquisa na Alemanha para Inovações em Agricultura Biológica
Foco em soluções biológicas promete aumentar produtividade e enfrentar estresses climáticos
Ler Mais
IBGE: Inflação de Transportes Tem Alta Moderada em Março
Reduções nas tarifas de ônibus ajudaram a conter elevações nos índices.
Ler MaisÚltimas Notícias
Ver todas →
Ministro do STF André Mendonça movimenta cena política com decisão sobre CPI
Prorrogação da CPI do INSS levanta debates acalorados e gera desdobramentos políticos

Sergio Moro Retoma Relações com Flávio Bolsonaro e Prepara Candidatura ao Governo do Paraná
Após crise turbulenta, ex-juiz se reintegra ao PL com planos ambiciosos enquanto o cenário político no Paraná se agita.

A Transição de Geraldo Leite Rosa Neto: De Comandante a Detento
Análise do impacto psicológico e social da prisão sobre um ex-oficial militar

Cláudio Castro Enfrenta Oito Anos de Inelegibilidade e Incertezas no Palácio Guanabara
Ex-governador do Rio de Janeiro vê suas chances políticas ameaçadas após condenação por abuso de poder.

Reflexões sobre os Objetos do Cotidiano e sua Relevância
A beleza das pequenas invenções que nos cercam e sua importância no dia a dia.

Obesidade: Uma Doença ou Uma Questão de Estilo de Vida?
Debates científicos e sociais em torno da classificação da obesidade como doença

Mulheres no Comércio Ambulante: Desafios e Ações na Busca por Igualdade
A invisibilidade das vendedoras ambulantes em debates globais sobre gênero e economia

Os Efeitos da Tensão no Oriente Médio sobre a Atração de Capital no Golfo
Como a escalada entre EUA e Irã pode afetar a reputação financeira da região.
Economia
Ver todas →
Os Efeitos da Tensão no Oriente Médio sobre a Atração de Capital no Golfo
Como a escalada entre EUA e Irã pode afetar a reputação financeira da região.

Os Desafios da Jornada de Trabalho e a Economia Brasileira
Análise crítica sobre a proposta de redução da carga horária e seus efeitos reais na produtividade.

EUA vs China: O Fim do Sonho Americano e o Trade-off da Pobreza
Análise do declínio das oportunidades econômicas nos Estados Unidos.
Mercado
Ver todas →
Segurança em Laboratórios da Unicamp Sob Suspeita Após Desaparecimento de Amostras Biológicas
Incidente gera preocupações sobre controle e proteção em ambientes de pesquisa crítica

Pagamentos B2B no Brasil: 77% são realizados a prazo, aponta estudo
Levantamento da Qive revela que crédito e a utilização de boletos dominam o setor.

Vale S.A. Registra Valorização em Dia de Alta Geral no Mercado
Ações da mineradora se destacam apesar da queda nos contratos futuros de minério de ferro.
Clima
Ver todas →
El Niño: Impactos Sobretudo nas Regiões Norte e Sul do Brasil
Previsões indicam efeitos variados entre as áreas do país, afetando principalmente a agricultura.

Instabilidades Climáticas e Chuvas no Brasil nesta Quinta-feira
Diferentes regiões do país enfrentam pancadas de chuva e altas temperaturas

Frente Fria Provoca Chuvas no Sul e Sudeste do Brasil
Previsões indicam instabilidades e pancadas de chuva em várias regiões, com possibilidade de intensidade moderada a forte.